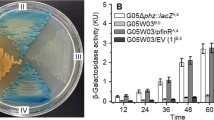

Abstract
Due to the inappropriate use of florfenicol in agricultural practice, florfenicol resistance has become increasingly serious. In this work, we studied the novel florfenicol resistance mechanism of an animal-derived Leclercia adecarboxylata strain R25 with high-level florfenicol resistance. A random genomic DNA library was constructed to screen the novel florfenicol resistance gene. Gene cloning, gene knockout, and complementation combined with the minimum inhibitory concentration (MIC) detection were conducted to determine the function of the resistance-related gene. Sequencing and bioinformatics methods were applied to analyze the structure of the resistance gene-related sequences. Finally, we obtained a regulatory gene of an RND (resistance-nodulation-cell division) system, ramA, that confers resistance to florfenicol and other antibiotics. The ramA-deleted variant (LA-R25ΔramA) decreased the level of resistance against florfenicol and several other antibiotics, while a ramA-complemented strain (pUCP24-prom-ramA/LA-R25ΔramA) restored the drug resistance. The whole-genome sequencing revealed that there were five RND efflux pump genes (mdtABC, acrAB, acrD, acrEF, and acrAB-like) encoded over the chromosome, and ramA located upstream of the acrAB-like genes. The results of this work suggest that ramA confers resistance to florfenicol and other structurally unrelated antibiotics, presumably by regulating the RND efflux pump genes in L. adecarboxylata R25.
Similar content being viewed by others
Avoid common mistakes on your manuscript.
Introduction
Florfenicol, a derivative of chloramphenicol with better antibacterial activity and fewer adverse effects, has been widely used in veterinary medicine (Schwarz and Chaslus-Dancla 2001; Schwarz et al. 2004). However, the resistance levels and the number of resistant bacteria to florfenicol have increased due to the ever-increasing use of florfenicol in agricultural practice (Chang et al. 2015; Geng et al. 2012; Sun et al. 2016). To date, more than ten florfenicol resistance genes have been reported. These genes belong to four molecular categories: the major facilitator superfamily (MFS, including floR, floRv, flost, fexA, fexB, and pexA) (Alessiani et al. 2014; Braibant et al. 2005; He et al. 2015; Kehrenberg and Schwarz 2004; Lang et al. 2010; Liu et al. 2012); the rRNA methyltransferase family [cfr, cfr(B), and cfr(C)] (Hansen and Vester 2015; Schwarz et al. 2000; Tang et al. 2017); the ATP-binding cassette (ABC) family (optrA) (Wang et al. 2015b); and a chloramphenicol acetate esterase-encoding gene, estDL136 (Tao et al. 2012). However, no efflux pump from RND family-related genes has been reported to be associated with florfenicol resistance.
The ramA global regulator belongs to the AraC/XylS family. Transcriptional regulators of the AraC/XylS family have been associated with multidrug resistance, organic solvent tolerance, oxidative stress, and virulence in Enterobacteriaceae (Gallegos et al. 1997). The ramA gene was first described in a multidrug-resistant (MDR) Klebsiella pneumoniae (George et al. 1995). Later, it was also discovered in Enterobacter aerogenes, Enterobacter cloacae, and Salmonella enterica (Bailey et al. 2008; Chollet et al. 2004; Keeney et al. 2007). Surprisingly, no ramA was identified in Escherichia coli. Previous studies showed that overexpression of the ramA gene in E. coli conferred decreased susceptibility to diverse antibiotics such as chloramphenicol, tetracycline, tigecycline, fluoroquinolones, and trimethoprim (Chollet et al. 2004; George et al. 1995). Concrete resistance mechanisms have been documented in E. cloacae and S. enterica serovar Typhimurium, where ramA-mediated overexpression of efflux pumps, primarily the AcrAB-TolC efflux pump, leads to increased tigecycline and ciprofloxacin resistance (Keeney et al. 2007; Sun et al. 2011). However, there are no available data regarding the role of the regulator gene ramA, which may potentially regulate the expression of other RND efflux pumps for florfenicol resistance.
Leclercia adecarboxylata, a motile, facultative anaerobic, Gram-negative bacillus of the Enterobacteriaceae family, is an opportunistic human pathogen that is normally present in environmental or animal sources (Stock et al. 2004; Yao et al. 2011). In this work, we used the random cloning approach to investigate the unidentified florfenicol resistance mechanism of a L. adecarboxylata strain R25 with the high florfenicol resistance level isolated from a rabbit anal feces sample.
Material and methods
The bacteria and plasmids
L. adecarboxylata R25 was isolated from an anal fecal sample of a rabbit during a survey of florfenicol-resistant bacteria from animal farms in 2015 in Wenzhou, Zhejiang Province, China, and it has been deposited in China Center for Type Culture Collection (CCTCC), Wuhan, China (CCTCC AB 2020046). The anal fecal samples were directly streaked on Luria-Bertani (LB) agar supplemented with 16 μg/mL florfenicol and cultured overnight at 37 °C. Bacterial identification was performed using a Vitek-60 microorganism autoanalysis system (BioMerieux Corporate, Craponne, France). The strain was further confirmed by the analysis of its 16S rRNA gene and a whole-genome sequence comparison of L. adecarboxylata R25 against the nucleotide database at NCBI (https://blast.ncbi.nlm.nih.gov/Blast.cgi). The bacterial strains and plasmids used in this study are listed in Table 1.
Whole-genome sequencing
Bacterial genomic DNA was extracted using an AxyPrep Bacterial Genomic DNA Miniprep Kit (Axygen Scientific, Union City, CA, USA). A 20-kb library was sequenced by PacBio RS II platform (Pacific Biosciences, Menlo Park, CA) and an Illumina library with 300-bp insert sizes sequenced from both ends was obtained with a HiSeq 2500 platform (both PacBio RS II and HiSeq 2500 sequencing were finished at Annoroad Gene Technology Co., Ltd, Beijing, China). The PacBio long reads were assembled using the Canu software (Koren et al. 2017) and the assembly quality was corrected with the Illumina short reads. Potential ORFs were predicted using Glimmer software (http://ccb.jhu.edu/software/glimmer) and annotated against a nonredundant protein database using the BLASTX program (https://blast.ncbi.nlm.nih.gov). The 16S rRNA sequences were annotated by the online tool RNAmmer (http://www.cbs.dtu.dk/services/RNAmmer/).
Random genomic DNA library construction and screening for potential florfenicol resistance genes
The genomic DNA of L. adecarboxylata R25 was extracted and partially digested with the Sau3AI enzyme. Fragments approximately 2 to 5 kb in size were retrieved from the gel and ligated into a pUC118 vector digested with BamHI. The ligated sample was transformed into competent E. coli DH5α cells, and the transformants containing the cloned fragments were then selected on LB agar plates containing ampicillin (100 μg/mL) and florfenicol (32 μg/mL). Plasmid DNA from the positive transformant was purified, and the recombinant plasmid was subjected to PCR for the detection of the known florfenicol resistance gene (floR) of L. adecarboxylata R25 (floR-F: 5′-ATGACCACCACACGCCCCGC-3′ and floR-R: 5′-TTAGACGACTGGCGACTTCT-3′). The inserted fragments of recombinants without a known florfenicol resistance gene were sequenced, and the ORF of the potential resistance gene was obtained.
Cloning of candidate resistance genes
Primers with restriction endonuclease adapters at both ends were used to clone the candidate gene with its potential upstream promoter region (Table 2). PrimeStarHS DNA Polymerase (TaKaRa, Dalian, China) was used to amplify the potential resistance genes according to the manufacturer’s instructions. The purified PCR product (prom-ORF) was digested with its corresponding restriction endonucleases and cloned into a pUCP24 vector that had been treated with the same restriction endonucleases. The resulting recombinant plasmid (pUCP24-prom-ORF) was transformed into E. coli DH5α using the calcium chloride method. The transformant was selected on LB agar plates containing 20 μg/mL gentamicin. The cloned PCR product was further confirmed by Sanger sequencing (ABI 3730 Analyzer, Foster City, CA, USA).
Construction of ramA-knockout and ramA-complemented strains
The inactivation of ramA in the wild-type strain L. adecarboxylata R25 was performed according to the method described by Datsenko and Wanner (Datsenko and Wanner 2000). Briefly, a kanamycin resistance gene (aph) flanked by FLP recognition target (FRT) sites in pKD4 was amplified by PCR using ramA-knockout-F/R primers and the template plasmid pKD4 under standard conditions. The ramA-knockout-F/R primers (Table 2) consisted of 20 nucleotides (nt) of the helper plasmid pKD4 and 50 nt of the 5′ and 3′ ends of the corresponding inactivated gene (ramA). The purified PCR fragment was digested with DpnI, purified, and transformed into L. adecarboxylata R25 by electroporation in the presence of pKD46 (carrying the Red recombinase gene). The mutant strain (LA-R25ΔramA-aph) was verified by PCR using the ramA-inner-F/R primers. The aph gene was further excised from LA-R25ΔramA-aph by the plasmid pCP20, which encodes FLP nuclease, introduced via transformation. Finally, the ramA-deleted variant was obtained and named LA-R25ΔramA.
The recombinant plasmid with ramA and its upstream predicted promoter region (pUCP24-prom-ramA) was transformed into the ramA-deleted strain (LA-R25ΔramA), and the transformant (pUCP24-prom-ramA/LA-R25ΔramA) was selected on LB agar containing 20 μg/mL gentamicin. The plasmid (pUCP24-prom-ramA) in the transformant (pUCP24-prom-ramA/LA-R25ΔramA) was confirmed by PCR with primers targeting ramA and further sequenced by Sanger sequencing.
Antibiotic susceptibility assay
The MICs of the antimicrobial agents against L. adecarboxylata R25 and other strains, including LA-R25ΔramA, pUCP24-prom-ramA/LA-R25ΔramA, and pUCP24-prom-ramA/E. coli DH5α, were determined by the standard agar dilution method recommended by CLSI-2017 (the Clinical and Laboratory Standards Institute in 2017). The measurements of MICs in the presence of the carbonyl cyanide m-chlorophenylhydrazone (CCCP) were also carried out by standard agar dilution method containing serial dilutions of six antibiotics (florfenicol, tetracycline, erythromycin, nalidixic acid, clarithromycin, and levofloxacin) in 18 mL of Mueller-Hinton broth (MHB), followed by the addition of 2 ml of CCCP (100 μg/mL in dimethyl sulfoxide [DMSO]) to give a final concentration of 10 μg/mL. The MIC was recognized as the lowest antibiotic concentration showing no colony growth. Each of the tests was carried out in triplicate. E. coli ATCC 25922 was used as a quality control strain.
qRT-PCR analysis of ramA mRNA concentration in L. adecarboxylata R25 and the recombinant strains
To validate the transcription level of the ramA gene in vivo, qRT-PCR was performed using the StepOne™ RT-PCR System (Applied Biosystems, USA) (Sanchez-Abarca et al. 2010). Total RNAs were extracted from the wild, mutant, and recombinant strains cultured in LB with or without florfenicol using the Trizol. cDNA was obtained by reverse transcription using the PrimeScript RT-PCR Kit (TaKaRa, Dalian, China). After qPCR analysis, relative quantification of the target in each sample was calculated using rpsL as the internal control (Mikhail et al. 2019).
Bioinformatic analysis of the genetic environment of ramA
Sequences containing the ramA gene were obtained from the NCBI nucleotide database by the BLAST program using an approximately 10-kb fragment (including the sequences of the upstream 1-kb region and the downstream 9-kb region of the ramA gene) of the L. adecarboxylata R25 genome sequence as the query. A total of 100 complete bacterial genome sequences sharing the greatest sequence identity with the 10-kb fragment of the L. adecarboxylata R25 genome were retrieved (until March 15th, 2018). The sequences were filtered to accept only those encoding at least one of the four genes (tetR, ramA, and acrA-, and acrB-like) with an amino acid identity ≥ 50%. The sequences were clustered into different groups according to the number and order of the four homologous genes. A representative sequence in each group was chosen as the candidate for structural comparative analysis.
Results
The antibiotics susceptibility of L. adecarboxylata R25 and resistance genes encoded in the L. adecarboxylata R25 genome
L. adecarboxylata R25 showed high resistance levels to florfenicol and chloramphenicol, with both MIC levels of 128 μg/mL. The strain also showed high resistance levels to several other antibiotics, such as tetracycline (MIC 256 μg/mL) and linezolid (MIC 128 μg/mL) (Table 3). The whole genome of L. adecarboxylata R25 (CP035382.1) consists of a circular chromosome (4.74 Mb) and two plasmids, pLA64 (64 kb, CP035381.1) and pLA109 (109 kb, CP035380.1). The functional annotation revealed that the whole genome encoded 9 drug resistance genes (mdfA, floR, aac(6′)-Ib-cr, arr-3, dfrA27, aadA16, qacEΔ1, sul1, and qnrB6). Of the 9 resistance genes, only one resistance gene floR was reported conferring resistance to florfenicol.
A randomly cloned ramA gene in E. coli conferring florfenicol resistance
A transformant with florfenicol and chloramphenicol resistance and free of the known florfenicol resistance gene was obtained from random cloning of R25 genomic DNA. The 2.8-kb insert fragment encoded three ORFs, including an MBL-fold metallohydrolase (mbl), a RamA family antibiotic efflux transcriptional regulator (ramA), and an outer membrane protease (omp), which shared 96, 100, and 54% amino acid identity with the top hits in the UniProtKB database, A0A2S4X220, A0A2T3CIN1, and A0A078LS26, respectively, of which the gene of RamA (A0A2T3CIN1) was from Enterobacter sp. FS01 isolated from parkland soil, Aarhus, Denmark. The minimum inhibitory concentration (MIC) results for the cloned genes with the predicted promotor regions (pUCP24-prom-ramA/DH5α, pUCP24-prom-omp/DH5α, pUCP24-prom-mbl/DH5α) showed that only the recombinant with ramA (pUCP24-prom-ramA/DH5α) was responsible for multidrug resistance, including resistance to florfenicol and chloramphenicol, and had the same MIC levels as the original transformant with the 2.8-kb insert fragment. The other two recombinants (pUCP24-prom-omp/DH5α and pUCP24-prom-mbl/DH5α) did not show any resistance to the antibiotics (Table 3).
Prominent functions of ramA in mediating antimicrobial resistance in L. adecarboxylata R25 and its derivatives
The recombinant strain pUCP24-prom-ramA/DH5α exhibited increased MIC levels against florfenicol (MIC increased from 64 to 1024 μg/mL, 8-fold), chloramphenicol (8-fold), linezolid (> 4-fold), tetracycline (8-fold), erythromycin (4-fold), tigecycline (8-fold), nalidixic acid (4-fold), and lincomycin (> 2-fold) relative to recipient E. coli DH5α or E. coli DH5α carrying the vector pUCP24 (pUCP24/DH5α) (Table 3). No differences in rifampicin, ampicillin, streptomycin, amikacin, and kanamycin resistance were observed among these strains. LA-R25ΔramA showed 2-fold decreased resistance levels against florfenicol and chloramphenicol relative to the parental strain L. adecarboxylata R25. After complementation with ramA (pUCP24-prom-ramA), the resistance levels of the recombinant (pUCP24-pro-ramA/LA-R25ΔramA) to florfenicol and chloramphenicol were fully recovered, with even higher resistance levels than the wild-type L. adecarboxylata R25 (MIC increased from 64 to 1024 μg/mL, 16-fold). Similar results were also found for the other antibiotics (Table 3). To further evaluate the role of ramA in the resistance of the strains to florfenicol, the transcription levels of ramA and its potential targets in L. adecarboxylata R25 were determined. It revealed that the wild strain L. adecarboxylata R25 cultured with florfenicol showed significantly higher transcription level of ramA than the one cultured without it. The ramA-complemented LA-R25ΔramA (pUCP24-pro-ramA/LA-R25ΔramA) which showed much higher MIC level to florfenicol (1024 μg/mL) than that (128 μg/mL) of the wild strain L. adecarboxylata R25 also showed significantly higher transcription level of ramA than that of the wild strain L. adecarboxylata R25 (Table 4). The expression levels of the potential target genes of ramA lowered in the ramA-deleted L. adecarboxylata R25 (LA-R25ΔramA) and recovered in ramA-complemented strain (pUCP24-pro-ramA/LA-R25ΔramA). They had (much) higher expression levels when the wild strain L. adecarboxylata R25 was treated with florfenicol (Table 4). It seemed that they were all regulated by ramA even though at different degrees.
To confirm if the florfenicol resistance of L. adecarboxylata R25 was related with the efflux pumps, CCCP was used as an inhibitory agent for the efflux pumps. CCCP itself exhibited an antimicrobial effect on L. adecarboxylata R25 and its derivatives with MICs of 20 μg/mL. We tested the MIC levels of the antibiotics combined with CCCP at a lower concentration (10 μg/mL). It showed that CCCP increased the sensitivity of L. adecarboxylata R25 and LA-R25ΔramA against florfenicol, tetracycline, and levofloxacin to 4- to 8-fold, but it did not show any effect on erythromycin, clarithromycin, and nalidixic acid (Table 5).
Structural comparison of the genetic environment of ramA and five RND systems encoded on the L. adecarboxylata R25 chromosome
Based on their similarity to the four ORFs (encoded by ramA and the other three genes in its neighboring region) in L. adecarboxylata R25, 96 sequences were chosen for further homology analysis. All were from chromosomes of species belonging to the family Enterobacteriaceae and were clustered into four groups. Four representative sequences from each group are illustrated in Fig. 1 and Table S1. Structural analysis of the four representatives showed that three of them contained a TetR family transcriptional regulator, which was absent in CP011662. Interestingly, the four representatives all contained two RND family efflux transporter genes, acrA-like and acrB-like. Moreover, a set of genes, including asmA, hp, kdgK, yhjJ, dctA, and yhjK were inserted between tetR and ramA in CP024834.
The chromosome of L. adecarboxylata R25 encoded four clusters of antibiotic resistance-related IMP-MFP genes and an IMP gene independent of the RND systems (Table 6 and Fig. 2). These genes included mdtABC, acrEF, acrAB, acrAB-like, and acrD. In the neighboring regions of the four clusters of IMP-MFP genes, the predicted regulators of RND systems were identified. These regulators were ramA, baeSR, ttgR, and acrR, respectively, of which only two (ramA and baeSR) were positive regulators (activating the transcription of the RND-type efflux pumps) (Fig. 2).
Genome map of L. adecarboxylata R25. The circles, from the inner to the outside: (1) the position in kb. (2) GC skew (G − C/G + C), with a positive GC skew toward the outside and a negative GC skew toward the inside. (3) GC content, with an average of 50%, and a G + C content of more than 50% is shown toward the outside; otherwise, inward. (4) Genes encoded in the leading strand (outwards) or the lagging strand (inwards). Genes with different functions are shown in different colors, and five groups of RND efflux pump-related elements are in red.
Discussion
It has been reported that ramA is associated with tigecycline and fluoroquinolone resistance, but its association with resistance to florfenicol has not been described. In this work, however, we found that a ramA gene encoded on the chromosome of L. adecarboxylata R25 was involved in resistance to florfenicol and several other antibiotics. This result was in accordance with previous observations that the ramA gene in S. enterica serovar Typhimurium or K. pneumoniae was associated with resistance to tigecycline and other antibiotics. Deletion of ramA resulted in increased susceptibility to antibiotics, and complementation with plasmid-borne ramA restored the parental phenotype of antimicrobial resistance (Horiyama et al. 2011; Wang et al. 2015a). These results confirmed that ramA played a role in bacterial resistance to florfenicol as well as other antibiotics.
The RND efflux pump system mainly consists of an inner membrane transporter protein such as AcrB, a periplasmic MFP such as AcrA, and an outer membrane channel protein such as TolC (Nikaido and biology 2011). All IMPs usually exist as trimers, and their external loops contain binding sites for ligands, while their transmembrane domains mainly function as a conduit for protons that serve as the energy source. During the export of substrates, IMPs undergo three consecutive conformational changes, including moving through access, binding, and extrusion conformations. In addition, with its broad substrate specificity, IMPs play their most important role in the RND efflux pump system. Previous studies have demonstrated that ramA is a regulatory factor involved in the upregulation of the expression of AcrAB and its paralogs, which mediate bacterial resistance to many chemical agents, including antibiotics. ramA in S. enterica serovar Typhimurium increases resistance to ciprofloxacin and other antimicrobial agents via upregulation of AcrAB expression (Sun et al. 2011). A similar study also showed that ramA upregulates the expression of AcrEF, a paralog of AcrAB, in S. enterica serovar Typhimurium (Bailey et al. 2010). A similar result was reported by Sheng et al., who demonstrated that a high ramA expression level in K. pneumonia was simultaneously accompanied by high expression of acrB, which conferred high resistance to tigecycline (Sheng et al. 2014). On the other hand, ramA-inactivated K. pneumoniae KP17 downregulated acrB, which decreased tigecycline resistance (Wang et al. 2015a). In this work, in accordance with these previous reports, the expression levels of the potential IMP genes (mdtB, mdtC, acrD, mdtF, acrB, and acrB-like) decreased in the ramA-deleted L. adecarboxylata R25 (LA-R25ΔramA) and recovered in ramA-complemented strain (pUCP24-pro-ramA/LA-R25ΔramA). These results demonstrated that RamA might activate the expression of some IMPs and enhance the antibiotic resistance of bacteria.
References
Alessiani A, Sacchini L, Pontieri E, Gavini J, Di Giannatale E (2014) Molecular typing of Salmonella enterica subspecies enterica serovar Typhimurium isolated in Abruzzo region (Italy) from 2008 to 2010. Vet Ital 50:31–39. https://doi.org/10.12834/VetIt.1304.07
Bailey AM, Paulsen IT, Piddock LJ (2008) RamA confers multidrug resistance in Salmonella enterica via increased expression of acrB, which is inhibited by chlorpromazine. Antimicrob Agents Chemother 52:3604–3611. https://doi.org/10.1128/AAC.00661-08
Bailey AM, Ivens A, Kingsley R, Cottell JL, Wain J, Piddock LJ (2010) RamA, a member of the AraC/XylS family, influences both virulence and efflux in Salmonella enterica serovar Typhimurium. J Bacteriol 192:1607–1616. https://doi.org/10.1128/JB.01517-09
Braibant M, Chevalier J, Chaslus-Dancla E, Pages JM, Cloeckaert A (2005) Structural and functional study of the phenicol-specific efflux pump FloR belonging to the major facilitator superfamily. Antimicrob Agents Chemother 49:2965–2971. https://doi.org/10.1128/AAC.49.7.2965-2971.2005
Chang SK, Lo DY, Wei HW, Kuo HC (2015) Antimicrobial resistance of Escherichia coli isolates from canine urinary tract infections. J Vet Med Sci 77:59–65. https://doi.org/10.1292/jvms.13-0281
Chollet R, Chevalier J, Bollet C, Pages JM, Davin-Regli A (2004) RamA is an alternate activator of the multidrug resistance cascade in Enterobacter aerogenes. Antimicrob Agents Chemother 48:2518–2523. https://doi.org/10.1128/AAC.48.7.2518-2523.2004
Datsenko KA, Wanner BL (2000) One-step inactivation of chromosomal genes in Escherichia coli K-12 using PCR products. Proc Natl Acad Sci U S A 97:6640–6645. https://doi.org/10.1073/pnas.120163297
Gallegos MT, Schleif R, Bairoch A, Hofmann K, Ramos JL (1997) AraC/XylS Family of Transcriptional Regulators. Microbiol Mol Biol Rev 61:393–410
Geng Y, Wang KY, Huang XL, Chen DF, Li CW, Ren SY, Liao YT, Zhou ZY, Liu QF, du ZJ, Lai WM (2012) Streptococcus agalactiae, an emerging pathogen for cultured ya-fish, Schizothorax prenanti, in China. Transbound Emerg Dis 59:369–375. https://doi.org/10.1111/j.1865-1682.2011.01280.x
George AM, Hall RM, Stokes HW (1995) Multidrug resistance in Klebsiella pneumoniae: a novel gene, ramA, confers a multidrug resistance phenotype in Escherichia coli. Microbiology 141:1909–1920
Hansen LH, Vester B (2015) A cfr-like gene from Clostridium difficile confers multiple antibiotic resistance by the same mechanism as the cfr gene. Antimicrob Agents Chemother 59:5841–5843. https://doi.org/10.1128/AAC.01274-15
He T, Shen J, Schwarz S, Wu C, Wang Y (2015) Characterization of a genomic island in Stenotrophomonas maltophilia that carries a novel floR gene variant. J Antimicrob Chemother 70:1031–1036. https://doi.org/10.1093/jac/dku491
Horiyama T, Nikaido E, Yamaguchi A, Nishino K (2011) Roles of Salmonella multidrug efflux pumps in tigecycline resistance. J Antimicrob Chemother 66:105–110. https://doi.org/10.1093/jac/dkq421
Keeney D, Ruzin A, Bradford PA (2007) RamA, a transcriptional regulator, and AcrAB, an RND-type efflux pump, are associated with decreased susceptibility to tigecycline in Enterobacter cloacae. Microb Drug Resist 13:1–6. https://doi.org/10.1089/mdr.2006.9990
Kehrenberg C, Schwarz S (2004) fexA, a novel Staphylococcus lentus gene encoding resistance to florfenicol and chloramphenicol. Antimicrob Agents Chemother 48:615–618. https://doi.org/10.1128/aac.48.2.615-618.2004
Koren S, Walenz BP, Berlin K, Miller JR, Bergman NH, Phillippy AM (2017) Canu: scalable and accurate long-read assembly via adaptive k-mer weighting and repeat separation. Genome Res 27:722–736. https://doi.org/10.1101/gr.215087.116
Lang KS, Anderson JM, Schwarz S, Williamson L, Handelsman J, Singer RS (2010) Novel florfenicol and chloramphenicol resistance gene discovered in Alaskan soil by using functional metagenomics. Appl Environ Microbiol 76:5321–5326. https://doi.org/10.1128/AEM.00323-10
Liu H, Wang Y, Wu C, Schwarz S, Shen Z, Jeon B, Ding S, Zhang Q, Shen J (2012) A novel phenicol exporter gene, fexB, found in enterococci of animal origin. J Antimicrob Chemother 67:322–325. https://doi.org/10.1093/jac/dkr481
Mikhail S et al. (2019) Evaluation of the synergy of ceftazidime-avibactam in combination with meropenem, amikacin, aztreonam, colistin, or fosfomycin against well-characterized multidrug-resistant Klebsiella pneumoniae and Pseudomonas aeruginosa 63:e00779-00719. https://doi.org/10.1128/AAC.00779-19
Nikaido HJAie, biology raom (2011) Structure and mechanism of RND-type multidrug efflux pumps 77:1
Sanchez-Abarca LI et al (2010) Immunomodulatory effect of 5-azacytidine (5-azaC): potential role in the transplantation setting. Blood 115:107–121. https://doi.org/10.1182/blood-2009-03-210393
Schwarz S, Chaslus-Dancla E (2001) Use of antimicrobials in veterinary medicine and mechanisms of resistance. Vet Res 32:201–225
Schwarz S, Werckenthin C, Kehrenberg C (2000) Identification of a Plasmid-Borne Chloramphenicol-Florfenicol Resistance Gene in Staphylococcus sciuri. Antimicrob Agents Chemother 44:2530–2533
Schwarz S, Kehrenberg C, Doublet B, Cloeckaert A (2004) Molecular basis of bacterial resistance to chloramphenicol and florfenicol. FEMS Microbiol Rev 28:519–542. https://doi.org/10.1016/j.femsre.2004.04.001
Sheng ZK et al (2014) Mechanisms of tigecycline resistance among Klebsiella pneumoniae clinical isolates. Antimicrob Agents Chemother 58:6982–6985. https://doi.org/10.1128/AAC.03808-14
Stock I, Burak S, Wiedemann B (2004) Natural antimicrobial susceptibility patterns and biochemical profiles of Leclercia adecarboxylata strains. Clin Microbiol Infect 10:724–733. https://doi.org/10.1111/j.1469-0691.2004.00892.x
Sun Y, Dai M, Hao H, Wang Y, Huang L, Almofti YA, Liu Z, Yuan Z (2011) The role of RamA on the development of ciprofloxacin resistance in Salmonella enterica serovar Typhimurium. PLoS One 6:e23471. https://doi.org/10.1371/journal.pone.0023471
Sun F et al (2016) Genetic characterization of a novel blaDIM-2-carrying megaplasmid p12969-DIM from clinical Pseudomonas putida. J Antimicrob Chemother 71:909–912. https://doi.org/10.1093/jac/dkv426
Tang Y, Dai L, Sahin O, Wu Z, Liu M, Zhang Q (2017) Emergence of a plasmid-borne multidrug resistance gene cfr(C) in foodborne pathogen campylobacter. J Antimicrob Chemother 72:1581–1588. https://doi.org/10.1093/jac/dkx023
Tao W et al (2012) Inactivation of chloramphenicol and florfenicol by a novel chloramphenicol hydrolase. Appl Environ Microbiol 78:6295–6301. https://doi.org/10.1128/AEM.01154-12
Wang X et al (2015a) Genetic characterisation of clinical Klebsiella pneumoniae isolates with reduced susceptibility to tigecycline: role of the global regulator RamA and its local repressor RamR. Int J Antimicrob Agents 45:635–640. https://doi.org/10.1016/j.ijantimicag.2014.12.022
Wang Y, Lv Y, Cai J, Schwarz S, Cui L, Hu Z, Zhang R, Li J, Zhao Q, He T, Wang D, Wang Z, Shen Y, Li Y, Feßler AT, Wu C, Yu H, Deng X, Xia X, Shen J (2015b) A novel gene, optrA, that confers transferable resistance to oxazolidinones and phenicols and its presence in Enterococcus faecalis and Enterococcus faecium of human and animal origin. J Antimicrob Chemother 70:2182–2190. https://doi.org/10.1093/jac/dkv116
Yao Q, Zeng Z, Hou J, Deng Y, He L, Tian W, Zheng H, Chen Z, Liu JH (2011) Dissemination of the rmtB gene carried on IncF and IncN plasmids among Enterobacteriaceae in a pig farm and its environment. J Antimicrob Chemother 66:2475–2479. https://doi.org/10.1093/jac/dkr328
Acknowledgments
The authors would like to acknowledge all study participants and individuals who contributed to the study.
Funding
This study was supported by the Science and Technology Project of Lishui City, China (Grant No. 2017GYX07), and the Natural Science Foundation of Zhejiang Province, China (Grant Nos. LQ17H190001 and LY19C060002).
Author information
Authors and Affiliations
Contributions
CC, YY, LZ, and AL collected the strains and performed the experiments. CC, YY, JL, and MZ analyzed the experimental results and performed the bioinformatics analysis. CC, YY, QB, and AL wrote the manuscript. QB, MZ, and AL designed the experiments. All authors read and approved the final manuscript.
Corresponding author
Ethics declarations
Conflict of interest
The authors declare no conflict of interest.
Human and ethical standards
The authors declare that the research comply with the guidelines for human studies and should include evidence that the research was conducted ethically in accordance with the World Medical Association Declaration of Helsinki.
Additional information
Publisher’s note
Springer Nature remains neutral with regard to jurisdictional claims in published maps and institutional affiliations.
Electronic supplementary material
ESM 1
(DOC 104 kb)
Rights and permissions
Open Access This article is licensed under a Creative Commons Attribution 4.0 International License, which permits use, sharing, adaptation, distribution and reproduction in any medium or format, as long as you give appropriate credit to the original author(s) and the source, provide a link to the Creative Commons licence, and indicate if changes were made. The images or other third party material in this article are included in the article's Creative Commons licence, unless indicated otherwise in a credit line to the material. If material is not included in the article's Creative Commons licence and your intended use is not permitted by statutory regulation or exceeds the permitted use, you will need to obtain permission directly from the copyright holder. To view a copy of this licence, visit http://creativecommons.org/licenses/by/4.0/.
About this article
Cite this article
Cheng, C., Ying, Y., Zhou, D. et al. RamA, a transcriptional regulator conferring florfenicol resistance in Leclercia adecarboxylata R25. Folia Microbiol 65, 1051–1060 (2020). https://doi.org/10.1007/s12223-020-00816-2
Received:
Accepted:
Published:
Issue Date:
DOI: https://doi.org/10.1007/s12223-020-00816-2